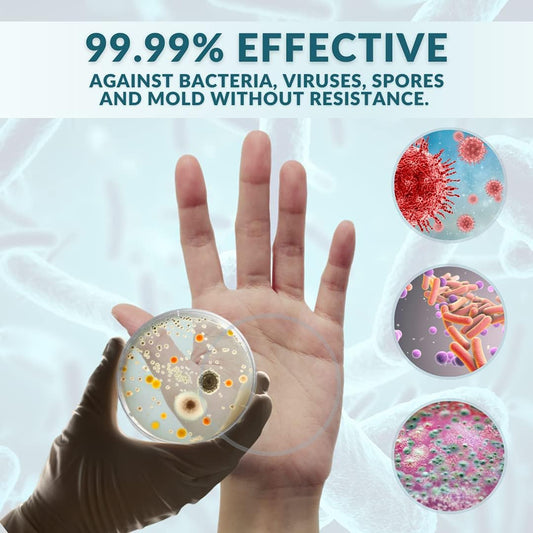
Esterilizante STERILOX, 1 L Spray

marque SterilOx
SterilOx révolutionne l'hygiène grâce à une technologie sûre et écologique. Il élimine 99,9 % des virus et bactéries sans produits chimiques agressifs. Idéal pour la maison, les animaux domestiques et un usage professionnel.
• Désinfectants
-
Prix habituel €10,00Prix habituelPrix unitaire par
Prix soldé €10,00Épuisé -
Prix habituel €12,00Prix habituelPrix unitaire par
Prix soldé €12,00Épuisé -
Prix habituel €5,00Prix habituelPrix unitaire par
Prix soldé €5,00Épuisé -
Prix habituel €3,00Prix habituelPrix unitaire par
Prix soldé €3,00Épuisé -
Prix habituel €18,00Prix habituelPrix unitaire par
Prix soldé €18,00 -
Prix habituel €24,00Prix habituelPrix unitaire par
Prix soldé €24,00Épuisé -
Prix habituel €18,00Prix habituelPrix unitaire par
Prix soldé €18,00Épuisé -
Prix habituel €30,00Prix habituelPrix unitaire par
Prix soldé €30,00Épuisé